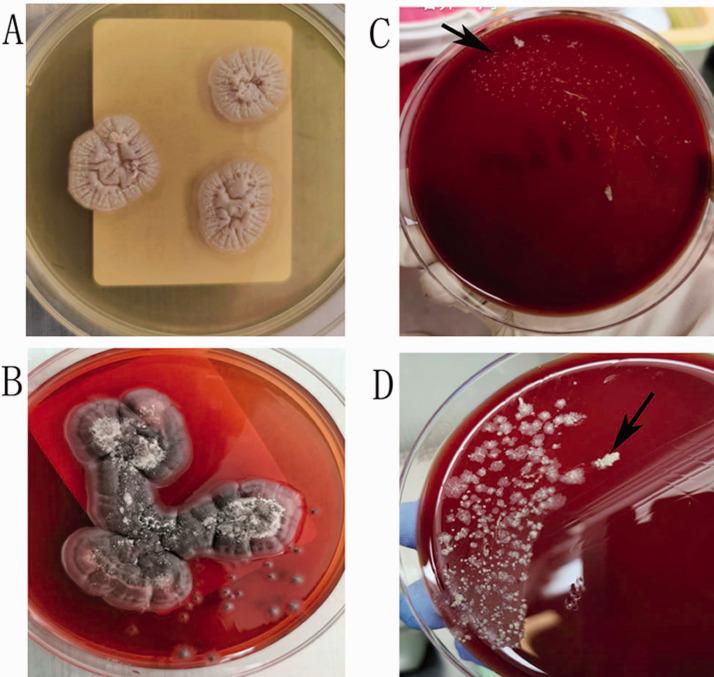
https://cdn.ncbi.nlm.nih.gov/pmc/blobs/1011/7809313/52ccd57969ce/10.1177_0300060520976471-fig2.jpg

一名抗干扰素-γ自身抗体阳性的人类免疫缺陷病毒阴性患者同时感染[具体病原体1]和[具体病原体2]:病例报告
Coinfection by and in a human immunodeficiency virus-negative patient with anti-interferon-γ autoantibody: a case report.
作者信息
Jin Weizhong, Liu Jianhong, Chen Kuang, Shen Ling, Zhou Yan, Wang Limin
机构信息
Department of Respiratory Medicine, Affiliated Hangzhou First People's Hospital, Zhejiang University School of Medicine, Hangzhou, Zhejiang, P.R. China.
Department of Respiratory Medicine, Jinhua Guangfu Hospital, Zhejiang, P.R. China.
出版信息
J Int Med Res. 2021 Jan;49(1):300060520976471. doi: 10.1177/0300060520976471.
Patients with anti-interferon (IFN)-γ autoantibodies have weakened immune defenses against intracellular pathogens. Because of its low incidence and non-specific symptoms, diagnosis of anti-IFN-γ autoantibody syndrome is difficult to establish during the early stages of infection. Here, we report a patient with high titers of serum anti-IFN-γ autoantibodies suffering from opportunistic infections. The patient presented with intermittent fever for 2 weeks. During his first hospitalization, he was diagnosed with pulmonary infection and successfully treated with antifungal therapy. However, multiple cervical lymph nodes subsequently became progressively enlarged. infection was confirmed by positive cervical lymph node tissue cultures. High-titer serum anti-IFN-γ antibodies were also detected. Following anti- therapy, both his symptoms and lymph node lymphadenitis gradually improved. Anti-IFN-γ autoantibody syndrome should be considered in adult patients with severe opportunistic coinfections in the absence of other known risk factors.
患有抗干扰素(IFN)-γ自身抗体的患者对细胞内病原体的免疫防御能力减弱。由于其发病率低且症状不具特异性,抗IFN-γ自身抗体综合征在感染早期很难确诊。在此,我们报告一例血清抗IFN-γ自身抗体滴度高且患有机会性感染的患者。该患者出现间歇性发热2周。在其首次住院期间,被诊断为肺部感染,并通过抗真菌治疗成功治愈。然而,随后多个颈部淋巴结逐渐肿大。颈部淋巴结组织培养呈阳性,证实存在感染。同时也检测到高滴度血清抗IFN-γ抗体。经过抗治疗后,他的症状和淋巴结炎均逐渐改善。对于没有其他已知风险因素的严重机会性合并感染的成年患者,应考虑抗IFN-γ自身抗体综合征。